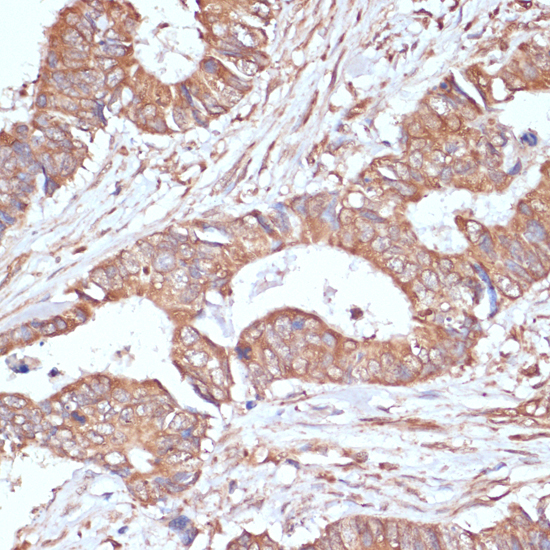
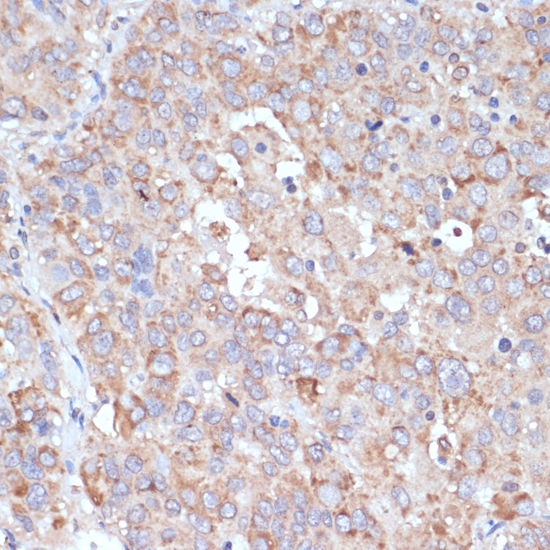

> Antigen, Antibodies, ELISA, Western Blot > Primary Antibody > Polyclonal Antibodies > YAP1 Polyclonal AntibodyBrand |
Leading Biology | Catalog Number |
APR23509N |
Product Type |
Polyclonal Antibodies | Field of Research |
Cell Biology & Developmental Biology>Hippo Signaling Pathway |
Product Overview |
We constantly strive to ensure we provide our customers with the best antibodies. As a result of this work we offer this antibody in purified format.
We are in the process of updating our datasheets. If you have any questions regarding this update, please feel free to contact our technical support team.
This product is a high quality YAP1 Polyclonal Antibody.
|
||
Molecular Weight |
Calculated MW:
36kDa/48kDa/49kDa/50kDa/52kDa/53kDa/54kDa
Observed MW:
75kDa
|
||
Species Reactivity |
Rabbit
|
||
Immunogen |
A synthetic peptide of human YAP1.
|
||
Cross Reactivity |
Human,Mouse,Rat
|
||
Isotype |
IgG
|
||
GeneID |
|||
UniProt ID |
|||
Purity |
Affinity purification |
||
Storage & Stability |
Store at +4°C short term. For long-term storage, aliquot and store at -20°C or below. Stable for 12 months at -20°C. Avoid repeated freeze-thaw cycles.
|
||
Storage Buffer |
Buffer: PBS with 50% glycerol, pH7.3.
|
||
Applications |
WB,IHC
|
||
Dilution |
WB 1:500 - 1:2000IHC 1:50 - 1:200
|
||
Product Description |
This gene encodes a downstream nuclear effector of the Hippo signaling pathway which is involved in development, growth, repair, and homeostasis. This gene is known to play a role in the development and progression of multiple cancers as a transcriptional regulator of this signaling pathway and may function as a potential target for cancer treatment. Alternative splicing results in multiple transcript variants encoding different isoforms.
|
||
Synonyms |
YAP1; COB1; YAP; YAP2; YAP65; YKI; Yes associated protein 1
|
||
Images |

Western blot analysis of extracts of various cell lines, using YAP1 antibody.
Immunohistochemistry of paraffin-embedded human colon carcinoma using YAP1 antibody.
Immunohistochemistry of paraffin-embedded human liver cancer using YAP1 antibody. |
||
Specification |
|||
Quantity |
|
||
| Select | Brand | Catalog No. | Product Name | Pack Size | Type | Field of Research | Specification | Quantity | Price(USD) | |
| 1 | Leading Biology | APR03440G | ITGA11 Antibody (N-term) | 100 μl | Polyclonal Antibodies |
|
$495.00 | Add Ask | ||
| 2 | Leading Biology | APR04537G | CMIP Antibody (C-term) | 100 μl | Polyclonal Antibodies |
|
$495.00 | Add Ask | ||
| 3 | Leading Biology | APR12422G | Human H4 Histamine Receptor (extracellular) Antibody | 50 μl | Polyclonal Antibodies |
|
$695.00 | Add Ask | ||
| 4 | Leading Biology | APR03844G | UBE2W Antibody (C-term) | 100 μl | Polyclonal Antibodies |
|
$495.00 | Add Ask | ||
| 5 | Leading Biology | APR04349G | HECTD2 Antibody (N-term) | 100 μl | Polyclonal Antibodies |
|
$495.00 | Add Ask | ||
| 6 | Leading Biology | APR03502G | IGHG1 Antibody (Center) | 100 μl | Polyclonal Antibodies |
|
$495.00 | Add Ask |
 Leading Biology Inc.
2600 Hilltop DR, Building G, B Suite C138
Richmond, CA, 94806
Tel: 1-661-524(LBI)-0262
Email: info@leadingbiology.com
Leading Biology Inc.
2600 Hilltop DR, Building G, B Suite C138
Richmond, CA, 94806
Tel: 1-661-524(LBI)-0262
Email: info@leadingbiology.com
Complete this form and click send to ask us a question, request a quote or simply say hello.

You have 0 item in your cart

You have 0 item in your inquiry list
